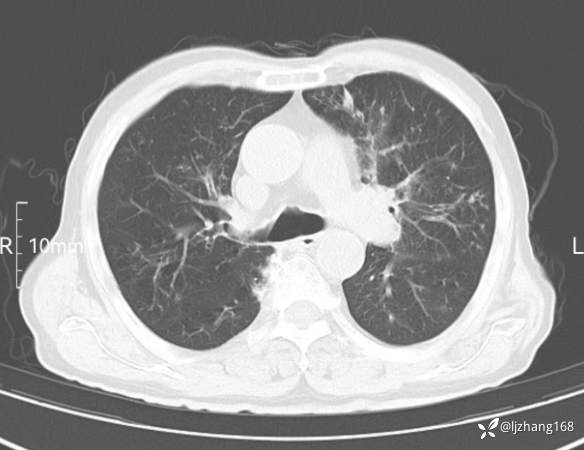
img

老年男患,咳嗽,气短,双肺多发间质性病变,何种感染?(有结果)
胡志勇HZY 达人已点赞患者性别:男
患者年龄:81岁
主诉:反复喘息、气短2年,再发加重伴咳嗽2天
简要病史:患者2年来反复于受凉后出现喘息、气短不适,活动后明显,休息时缓解,偶有咳嗽,咳少量白色泡沫痰,痰量较少,不易咳出,每年秋冬季节较易发作,每年发作累计病程约大于3月,无明显双下肢水肿,多次就诊于外院治疗(具体不详)后好转出院。院外症状仍间断发作。2天前患者感喘累症状加重,稍事活动即感喘累,休息后缓解不明显,双下肢无水肿,伴阵发性咳嗽,无明显咳痰,就诊于当地县医院治疗无明显缓解。急诊以“慢性阻塞性肺疾病”收入院。病来精神、睡眠、饮食欠佳,大小便如常。近期体重无明显增减。 既往史:高血压病史20⁺年,既往最高达190/? mmHg,院外规律口服药物(具体不详)控制血压,诉平日血压控制可;否认“肝炎、结核及伤寒”等传染病史,否认“糖尿病、肾病”等病史,否认食物及药物过敏史。否认输血及手术史;无吸烟及饮酒史。预防接种史不详。
体格检查:T 36.5℃,P 85次/分,R 16次/分,BP 140/73mmHg,SP02 95%,急性面容,精神一般,查体合作,口唇及甲床无发绀,咽部无充血,扁桃体不大,颈软,颈静脉无充盈,浅表淋巴结未扪及,桶状胸,肋间隙稍增宽,双肺呼吸音粗,双肺闻及弥漫哮鸣音及散在湿啰音,无胸膜摩擦音。心界不大,心率85次/分,律齐,各瓣膜听诊区未闻及明显病理性杂音。腹平软,无压痛、反跳痛及肌紧张,肝脾未扪及,双肾区无叩痛,双下肢无水肿。生理反射存在,病理反射未引出。
辅助检查:胸部CT:双肺肺气肿,间质性病变,血气分析:PH 7.413, PCO2 29.2mmHg, PO2,81.8mmHg,乳酸 3.3mmol/1,剩余碱-4.0mmol/1,HC03 18.8mmol/1。全血超敏C反应蛋白:超敏C反应蛋白 135.60 mg/L、 白细胞 14x19^9/L,中性粒细胞11.6x10^9/L。
临床诊断:
治疗经过:
讨论:诊断及治疗